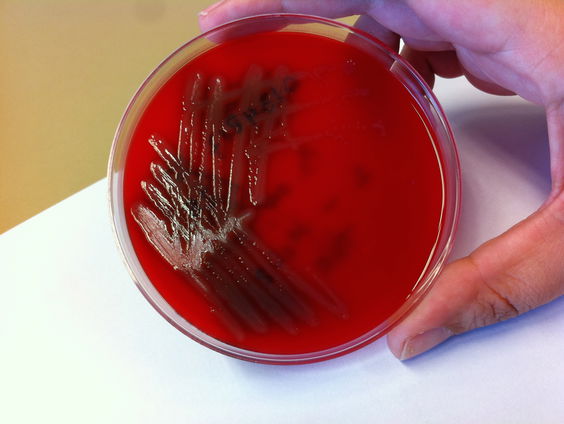
Wat als antibiotica niet meer werkt?

Uitzending gemist




De Nacht van NTR over collectieve rouw
- Gids
- De Nacht van NTR over collectieve rouw
Gepresenteerd door: Stijn Goossens
Voor de graveyard shift van NPO Radio 1 slaan vijf omroepen de handen ineen. De NTR, EO, KRO-NCRV, BNNVARA en Omroep ZWART nemen elk één nacht voor hun rekening. Jonge makers creëren nachtradio waar je wakker van ligt, met onderwerpen waar je wakker voor wilt blijven. Zowel onvoorspelbaar als kwetsbaar, met een intimiteit die alleen de nacht kan bieden.
In ‘De Nacht van…’ krijgen studiogasten nog écht de ruimte voor hun verhaal en als luisteraar kan je elke uitzending meepraten. Maak kennis met Nederlanders van over de hele wereld en luister naar de mooiste audioverhalen van NPO Radio 1. Elke werknacht tussen 02.00 en 05.00 uur.